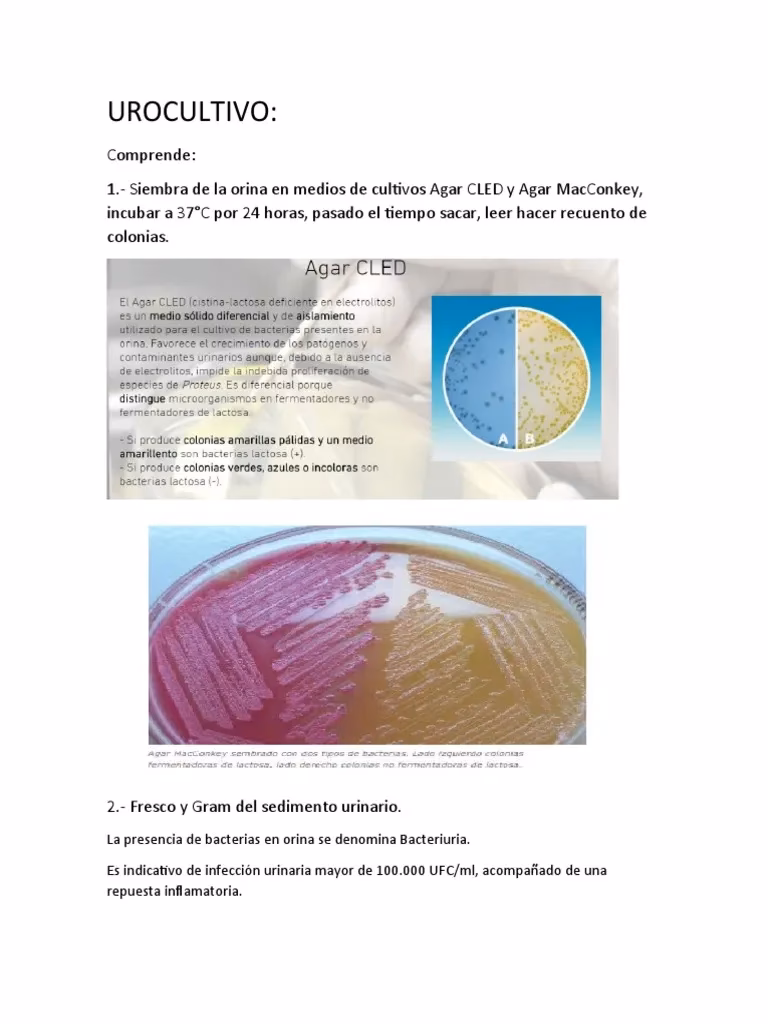
¿Cuándo es necesario pedir un urocultivo?

04/07/2020
Cuando sentimos molestias al orinar, dolor en la parte baja del abdomen o una necesidad constante de ir al baño, es común pensar en una infección urinaria. Si bien los síntomas pueden ser muy claros, para confirmar el diagnóstico y, sobre todo, para encontrar el tratamiento más efectivo, existe una prueba de oro: el urocultivo. A menudo confundido con un simple análisis de orina, el urocultivo es una herramienta diagnóstica mucho más profunda y específica. En este artículo, desglosaremos todo lo que necesitas saber sobre él, desde qué es y cuándo es necesario, hasta cómo interpretar sus resultados.
- ¿Qué es Exactamente un Urocultivo y Por Qué es Tan Importante?
- Urocultivo vs. Análisis General de Orina: La Diferencia Clave
- ¿Cuándo es Realmente Necesario Solicitar un Urocultivo?
- La Recolección de la Muestra: Un Paso Crítico para un Resultado Fiable
- Interpretando los Resultados: ¿Qué Significan Esos Números?
- Preguntas Frecuentes (FAQ)
- Conclusión: Una Herramienta Precisa para un Diagnóstico Correcto
¿Qué es Exactamente un Urocultivo y Por Qué es Tan Importante?
El cultivo de orina, conocido comúnmente como urocultivo, es un análisis de laboratorio diseñado para detectar y, fundamentalmente, identificar la presencia de microorganismos, principalmente bacterias, en la orina. El tracto urinario superior, que incluye los riñones y la vejiga, es un ambiente normalmente estéril, lo que significa que no debería haber gérmenes allí. La presencia de una cantidad significativa de bacterias suele ser un indicador claro de que se ha producido una infección.
El proceso es fascinante en su simplicidad y eficacia. Una muestra de tu orina se coloca en una placa con un medio de cultivo, que es una sustancia gelatinosa rica en nutrientes que favorece el crecimiento bacteriano. Esta placa se incuba a una temperatura corporal ideal durante 24 a 72 horas. Si hay bacterias en la muestra, estas se multiplicarán y formarán colonias visibles. El laboratorio no solo confirma su presencia, sino que también identifica el tipo específico de bacteria causante de la infección (como la famosa Escherichia coli) y determina qué antibióticos son efectivos contra ella a través de una prueba complementaria llamada antibiograma. Esto es crucial para evitar el uso de antibióticos ineficaces y combatir la creciente resistencia bacteriana.
Urocultivo vs. Análisis General de Orina: La Diferencia Clave
Es un error muy común pensar que un análisis general de orina (EGO) es lo mismo que un urocultivo. Aunque ambos usan una muestra de orina, sus objetivos son muy diferentes. El análisis general de orina es una prueba de detección rápida que busca signos indirectos de un problema, como la presencia de leucocitos (glóbulos blancos que combaten infecciones), sangre (hematuria) o nitritos (un subproducto de algunas bacterias). Si bien es útil, es inespecífico. Varias condiciones, desde un cálculo renal hasta una enfermedad de transmisión sexual, pueden alterar sus resultados.
Podríamos decir que el análisis general de orina ve el "humo" (la inflamación), mientras que el urocultivo identifica la "fuente del fuego" (la bacteria específica). Aquí te presentamos una tabla comparativa para aclarar las diferencias:
| Característica | Análisis General de Orina (EGO) | Urocultivo |
|---|---|---|
| Objetivo Principal | Detectar anomalías generales (inflamación, sangre, etc.). | Identificar el microorganismo causante de una infección. |
| ¿Qué detecta? | Leucocitos, nitritos, sangre, células epiteliales, cristales. | Crecimiento de colonias bacterianas y su tipo específico. |
| Tiempo de resultado | Pocas horas. | 48 a 72 horas. |
| Información sobre tratamiento | Ninguna. Sugiere una posible infección, pero no guía el tratamiento. | Proporciona un antibiograma que indica qué antibióticos son eficaces. |
¿Cuándo es Realmente Necesario Solicitar un Urocultivo?
Si has tenido una cistitis (infección de vejiga) simple y tu médico te recetó un antibiótico sin pedirte un examen, no te alarmes. En mujeres jóvenes con síntomas típicos de una infección no complicada, es una práctica común y aceptada iniciar el tratamiento de forma empírica, ya que la probabilidad de éxito es alta y esperar 3 días por el resultado podría prolongar el malestar. Sin embargo, hay situaciones específicas donde el urocultivo es indispensable:
- Síntomas atípicos o diagnóstico dudoso: Cuando el cuadro clínico no es claro, el urocultivo confirma si realmente hay una infección bacteriana.
- Fallo del tratamiento inicial: Si los síntomas persisten después de un primer ciclo de antibióticos, es vital saber qué bacteria está causando el problema y a qué es resistente.
- Sospecha de pielonefritis: Si la infección ha ascendido a los riñones (causando fiebre alta, dolor de espalda y malestar general), el urocultivo es mandatorio para guiar un tratamiento más agresivo.
- Durante el embarazo: Las infecciones urinarias en embarazadas, incluso sin síntomas (bacteriuria asintomática), deben ser tratadas para evitar complicaciones como parto prematuro. El urocultivo es una prueba de rutina.
- Infecciones urinarias recurrentes: En personas que sufren infecciones de forma repetida, es fundamental identificar el germen para establecer una estrategia de tratamiento y prevención a largo plazo.
- En hombres y niños: Las infecciones urinarias son menos comunes en estos grupos y suelen requerir una investigación más profunda, empezando por un urocultivo.
- Antes de procedimientos urológicos: Para prevenir infecciones postoperatorias, se realiza un urocultivo para asegurar que la orina esté libre de bacterias antes de una cirugía o procedimiento invasivo.
La Recolección de la Muestra: Un Paso Crítico para un Resultado Fiable
Un resultado preciso depende enormemente de una recolección de muestra adecuada. El objetivo es obtener orina de la vejiga, evitando la contaminación con bacterias de la piel o la zona genital. Una muestra contaminada puede llevar a un diagnóstico erróneo y a un tratamiento innecesario. Sigue estos pasos cuidadosamente:
- Utiliza el recipiente adecuado: El laboratorio te proporcionará un frasco estéril. No lo abras hasta el momento de usarlo y no toques su interior.
- Higiene de manos: Lávate bien las manos con agua y jabón antes de empezar.
- Limpieza de la zona genital: Este es el paso más importante. Las mujeres deben separar los labios mayores y limpiar la zona del meato uretral con una gasa estéril o una toallita antiséptica, siempre de adelante hacia atrás. Los hombres deben retraer el prepucio y limpiar la punta del pene.
- Técnica del chorro medio: Comienza a orinar en el inodoro. Descarta esta primera parte del chorro, ya que sirve para "limpiar" la uretra. Sin detener el flujo, coloca el frasco estéril y recoge la porción media de la orina hasta llenarlo aproximadamente hasta la mitad. Termina de orinar en el inodoro.
- Entrega rápida: Cierra bien el frasco y entrégalo en el laboratorio lo antes posible, idealmente en menos de una hora. Si no es posible, debes refrigerarlo (no congelarlo) por un máximo de 24 horas.
Consejo profesional: La primera orina de la mañana es la muestra ideal, ya que ha estado concentrándose en la vejiga durante varias horas, lo que permite que cualquier bacteria presente se multiplique a niveles más fácilmente detectables.
Interpretando los Resultados: ¿Qué Significan Esos Números?
Una vez que el laboratorio emite el informe, puede parecer confuso. Aquí te ayudamos a entenderlo:
- Resultado Negativo: Significa que no hubo crecimiento bacteriano significativo después del período de incubación. En general, descarta una infección urinaria bacteriana.
- Resultado Positivo: Se considera positivo cuando el recuento de colonias es igual o superior a 100,000 Unidades Formadoras de Colonias por mililitro (UFC/ml). Este es el estándar de oro para el diagnóstico. El informe especificará el nombre de la bacteria y el antibiograma asociado.
- El Área Gris (Resultados ambiguos): A veces, el recuento se encuentra entre 10,000 y 100,000 UFC/ml. Este resultado puede indicar una infección incipiente o, más comúnmente, una contaminación de la muestra. En estos casos, el médico evaluará el resultado junto con tus síntomas y los hallazgos del análisis de orina general (como la presencia de leucocitos). Si se sospecha contaminación, es probable que se pida repetir la prueba.
Preguntas Frecuentes (FAQ)
¿Puedo tener una infección urinaria con un urocultivo negativo?
Es poco común, pero posible. Podría ocurrir si comenzaste a tomar antibióticos antes de recoger la muestra, si la infección es causada por un germen que no crece en los medios de cultivo estándar, o si los síntomas se deben a otra condición como una uretritis o una cistitis intersticial (no infecciosa).
¿Tener bacterias en la orina siempre significa que necesito antibióticos?
No necesariamente. Existe una condición llamada "bacteriuria asintomática", donde hay más de 100,000 UFC/ml en el urocultivo, pero la persona no tiene ningún síntoma. En la mayoría de los adultos sanos, esto no requiere tratamiento. Las excepciones principales son las mujeres embarazadas, pacientes que serán sometidos a cirugía urológica y personas con sistemas inmunitarios comprometidos.
¿Qué es exactamente el antibiograma?
Es la segunda parte del urocultivo positivo. Una vez identificada la bacteria, se expone a diferentes discos impregnados con varios antibióticos. El informe mostrará una lista de antibióticos y los clasificará como "Sensible" (S), "Resistente" (R) o "Intermedio" (I). Esto permite al médico elegir el antibiótico más eficaz y específico, asegurando la cura y minimizando el riesgo de resistencias.
Conclusión: Una Herramienta Precisa para un Diagnóstico Correcto
El urocultivo es mucho más que un simple análisis; es una herramienta de diagnóstico de precisión que permite a los médicos confirmar una infección urinaria, identificar al culpable y, lo más importante, seleccionar el arma correcta para combatirlo. Aunque no siempre es necesario para una primera infección no complicada, su valor en casos recurrentes, complejos o en poblaciones de riesgo es incalculable. Recuerda siempre que la clave para un buen resultado comienza contigo: una recolección de muestra limpia y cuidadosa. Al final, la regla de oro de la medicina prevalece: se debe tratar al paciente, no al resultado de un examen. Un urocultivo positivo sin síntomas no siempre requiere tratamiento, y un urocultivo negativo con síntomas claros puede requerir una investigación más profunda.
Si quieres conocer otros artículos parecidos a Urocultivo: La Guía Definitiva para Entenderlo puedes visitar la categoría Ecología.

